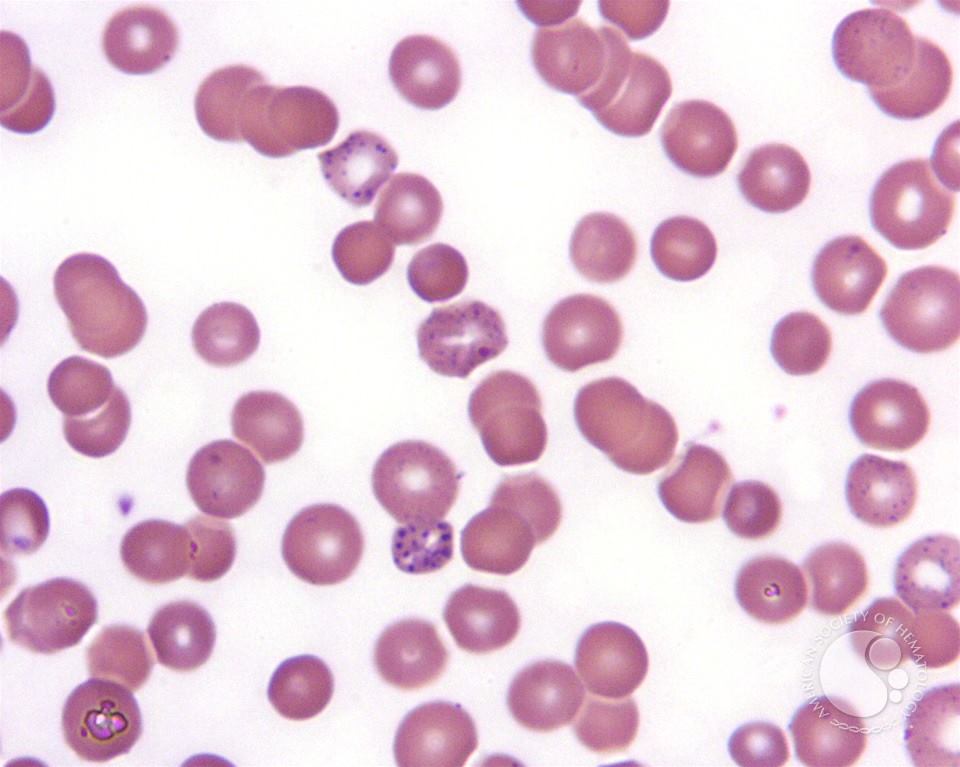
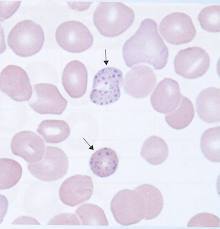

- Basophilic stippling is the occurrence of fine, medium, or coarse blue granules uniformly distributed throughout some red blood cells.
- Fine stippling may be associated with polychromatophilia, while coarse stippling usually indicates impaired erythropoiesis.
- Heavy metal poisoning (e.g. lead and arsenic), hemoglobinopathies, thalassemias, sideroblastic anemias, pyrimidine-5’-nucleotidase deficiency, and other diseases should be excluded when coarse basophilic stippling is found.